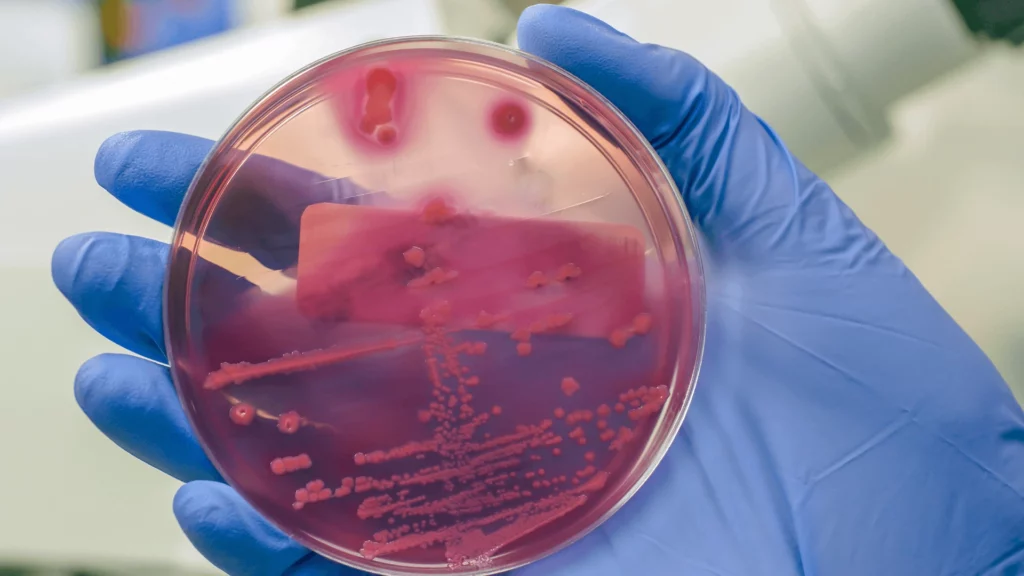
Odgrzybianie woj. Pomorskie

Ozonowanie
Ozonowanie mieszkania to jedna z najskuteczniejszych metod usuwania nieprzyjemnych zapachów, bakterii, wirusów i grzybów. Ozonowanie polega na wytwarzaniu ozonu – gazowego utleniacza, który ma silne właściwości dezynfekujące i neutralizujące. Proces ozonowania zaczyna się od umieszczenia w pomieszczeniu specjalnego generatora ozonu. Generator ten wytwarza ozon poprzez przepuszczenie przez elektrody powietrza, które następnie jest wprowadzane do pomieszczenia. W czasie ozonowania mieszkania, ozon penetruje przez każdy zakamarek, niszcząc bakterie, wirusy i grzyby, a także neutralizując nieprzyjemne zapachy. Ozonowanie mieszkania jest szczególnie skuteczne w przypadku problemów z zapachami, takimi jak dym papierosowy, zapachy z kuchni czy też zapachy pochodzące z łazienki. Ozonowanie również usuwa kurz i roztocza, co wpływa na poprawę jakości powietrza w pomieszczeniu. Ponadto, ozonowanie może pomóc w zwalczaniu alergii, astmy i innych chorób układu oddechowego, które mogą być wywołane przez obecność bakterii, wirusów i grzybów w powietrzu. Ważne jest, aby pamiętać, że ozonowanie mieszkania jest procesem, który wymaga specjalistycznej wiedzy i sprzętu. Bezpieczne i skuteczne ozonowanie wymaga również przestrzegania określonych zasad bezpieczeństwa. Przede wszystkim, pomieszczenia, które mają być ozonowane, muszą być całkowicie opróżnione z ludzi i zwierząt. Ozon może być szkodliwy dla zdrowia, a nawet toksyczny w wysokich stężeniach, więc należy przestrzegać określonych limitów czasowych ozonowania.
Ozonowanie to świetny sposób na pozbycie się w przestrzeni zamkniętej:
- wirusów,
- bakterii,
- grzybów,
- roztoczy,
- pleśni,
- drobnoustrojów.